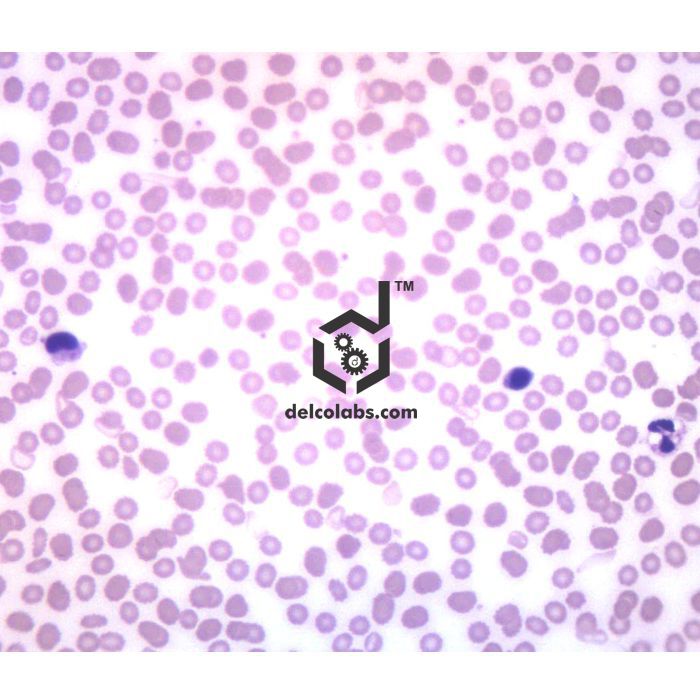

- Home
-
Products
Products
- Biology Biology
- Chemistry Chemistry
-
Electronic Trainers
Electronic Trainers
- Amplifier Trainers Analog Electronics Lab Communication Lab Trainers Consumer Electronics Lab Control Lab Trainers Digital Electronics Lab Display Boards Electrical Bridges Electronics Lab Trainers Function Generator Green Energy Based Trainers Instrumentation & Transducer Lab Microcontroller & Microprocessor Trainer Network Theorems Trainers Optical Fiber Lab Oscillators Physics Lab Experiment Setups Physics Lab Training Kits Power Electronics & Drive Lab
- Geography Geography
- Lab Chemicals Lab Chemicals
- Mathematics Mathematics
- Microscopes Microscopes
- Physics Physics
- About Us
- Search Alphabetically
- News & Events
- Contact Us
Call Us:
+91-9896793726